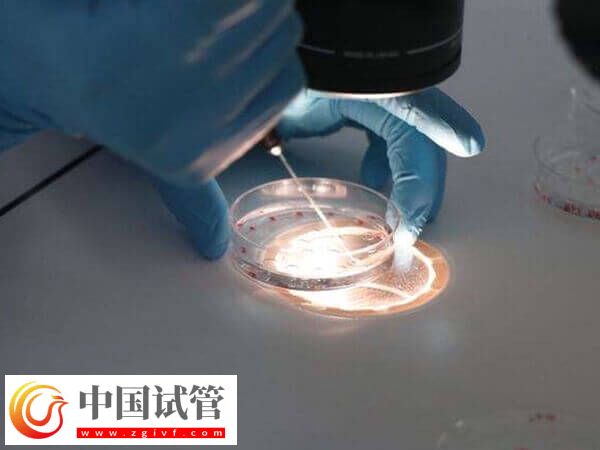
为什么试管养囊第6天才成功(图1)

为什么试管养囊第6天才成功
试管婴儿养囊是个优胜劣汰的过程,一般有的患者养囊五天就成功了,但有的患者精子和卵子质量相对较差,那么就会影响囊胚的发育潜力,从而导致囊胚在第六天才成功养出。此外,试管养囊第6天才成功,也可能是胚胎发育潜能低或是胚胎培养环境不佳所致,具体还要以实际情况进行判断。
试管养囊第6天才成功的原因
囊胚培养是指在试管婴儿的治疗中,将胚胎培养到囊胚阶段,这是胚胎发育的一个阶段,一般囊胚多在受精后5到7天形成,所以养囊养到第六天才成功养出囊胚也是正常的,至于为何养囊如此长时间才成功养出囊胚,其原因可能有以下几点:
精卵子质量差
养囊过程中因胚胎会受到卵子和精子的质量的影响,所以当卵子和精子的质量相对差时,可能会使胚胎发育不佳,进而直至在第6天才能成功养出囊胚,这是正常的表现。
胚胎发育潜能低
一般养囊养到第六天才成功,可能是有部分的受精卵受精后,本身由于发育较慢,所以在培育到6天才能看到胚胎的生长发育,这是胚胎的发育潜能低导致的现象。
胚胎培养环境不佳
胚胎培养环境不佳也是养囊养到第六天才成功的因素之一,所以如果患者要想成功养囊,那么最好选择试管胚胎培养比较好的机构进行,这样可获取质量好的囊胚。





